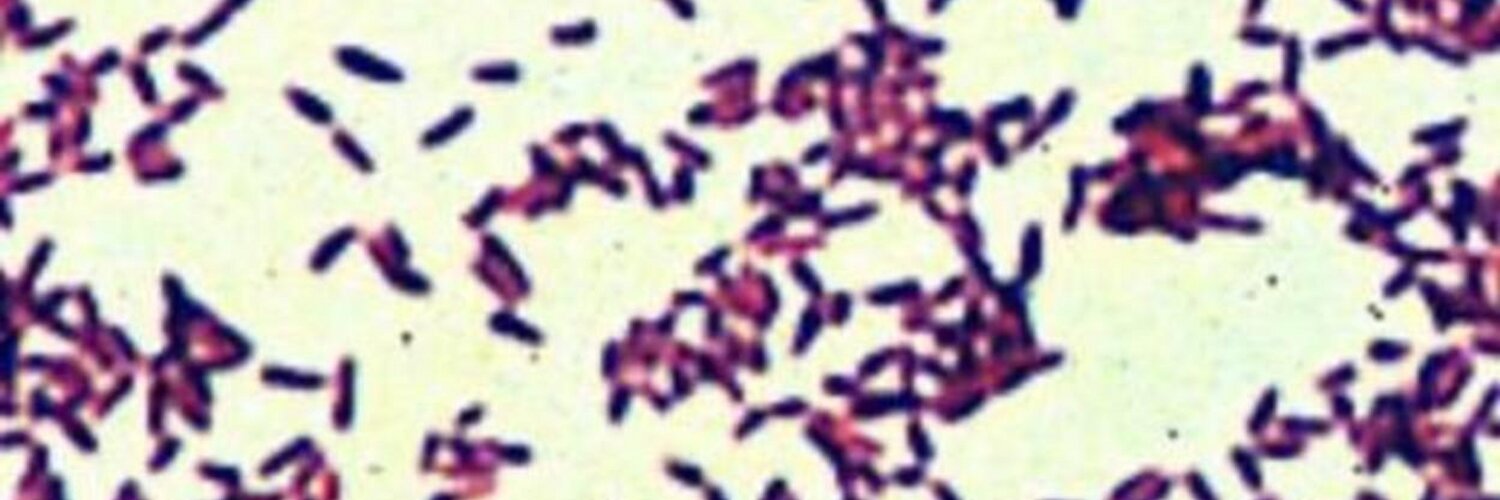

Дифтерийная палочка: Дифтерия и ее профилактика
Дифтерия
Дифтерия — инфекционное заболевание, вызываемое бактерией Corynebacterium diphtheriae (бацилла Лёффлера). Чаще всего поражает ротоглотку, но нередко затрагивает гортань, бронхи, кожу и другие органы. Инфекция передаётся воздушно-капельным путём. Возможен контактно-бытовой путь передачи, особенно в жарких странах, где часты кожные формы дифтерии. Тяжесть болезни обусловлена крайне ядовитым токсином, который выделяет дифтерийная палочка. Встречаются и доброкачественные формы, например дифтерия носа, которая протекает без выраженной интоксикации.
Если дифтерия поражает ротоглотку, то помимо тяжёлой интоксикации, возможно развитие крупа — закупорки дыхательных путей дифтерийной плёнкой и отёком, особенно у детей.
Возбудитель
Дифтерийная палочка — грамположительные палочковидные бактерии рода Corynebacterium. Впервые возбудитель был обнаружен на срезах плёнок, полученных из ротоглотки больных в 1883 г.
Corynebacterium diphtheriae — крупные, прямые, слегка изогнутые полиморфные палочковидные бактерии. На полюсах клеток локализуются метахроматические зёрна волютина, придавая клеткам характерную форму «булавы». Зёрна волютина окрашиваются метиленовым синим по Нейссеру. На микропрепаратах располагаются одиночно, или, вследствие особенностей деления клеток, располагаются в форме латинской буквы V или Y. Спор и капсул не образуют.
Источники инфицирования
Дифтерия является антропонозом, то есть резервуаром болезни выступают люди. Заражение здорового человека может произойти от:
- Больного дифтерией. Чем более выражена тяжесть, тем больше бактерий выделяет больной.
- Здорового носителя бактерии.
Пути передачи
- Воздушно-капельный (при кашле, чихании)
- Контактно-бытовой (через предметы, с которыми соприкасался больной)
- Пищевой — через заражённые продукты (молоко, сыр и пр.

Классификация
По локализации различают локализованную и распространённую формы дифтерии.
По формам и вариантам течения различают:
- Дифтерия ротоглотки:
- локализованная — с катаральным, островчатым и плёночным воспалением;
- распространённая — с налётами за пределами ротоглотки;
- субтоксическая, токсическая (I, II и III степени), гипертоксическая.
- Дифтерийный круп:
- локализованный — дифтерия гортани;
- распространённый — дифтерия гортани и трахеи;
- нисходящий — дифтерия гортани, трахеи, бронхов.
- Дифтерия других локализаций: носа, глаз, кожи, половых органов.
- Комбинированные формы дифтерии с одновременным поражением нескольких органов.
Клиническая картина
Грязно-белая плёнка на мягком нёбе, классический признак дифтерии.
Заболевание сопровождается следующими симптомами:
- Повышение температуры;
- Бледность кожных покровов;
- Выраженная слабость;
- Отёк мягких тканей шеи;
- Лёгкая боль в горле, затруднение глотания;
- Увеличение нёбных миндалин;
- Гиперемия и отёк слизистой глотки;
- Плёнчатый налёт (может быть любого цвета, но чаще всего бывает серо-белым), покрывающий нёбные миндалины и иногда распространяющийся на нёбные дужки, мягкое нёбо, боковые стенки глотки, гортань;
- Увеличение шейных лимфоузлов.

Дифтерия ротоглотки
Самой частой формой дифтерии (90—95 % всех случаев) является дифтерия ротоглотки. При локализованной форме налёты только на миндалинах. Интоксикация слабо выражена, температура до 38—39°С, головная боль, недомогание, незначительные боли при глотании. Наиболее типична плёнчатая (сплошная) форма дифтерии, при которой плёнка с очерченными краями покрывает всю миндалину, трудно снимается шпателем; при попытке её снятия, поверхность миндалины кровоточит; плёнка плотная; лимфатические узлы малоболезненны, подвижны. При островчатой форме налёты имеют вид островков различной величины, расположены чаще вне лакун, на внутренней стороне миндалин, края налётов неровные.
Распространённая дифтерия
При распространённой форме дифтерии, налёты распространяются за пределы миндалин на нёбные дужки и язычок. Интоксикация более выражена: отмечаются вялость, боль в горле. Регионарные лимфатические узлы увеличены до крупного боба, чувствительны, но отёка шейной клетчатки нет.
Токсическая дифтерия
При токсической, одной из самых тяжёлых форм дифтерии, заболевание начинается бурно, с первых часов температура повышается до 40°С, выражены вялость, сонливость, сильная слабость, головная боль и боль в горле, иногда боль в шее и в животе. Появляются гиперемия и отечность зева, налёты, вначале нежные желеобразные в виде паутинообразной сетки. Ко 2—3-му дню налёты становятся толстыми, грязно-серого цвета, полностью покрывают миндалины, дужки, язычок, мягкое и твёрдое нёбо.
Дыхание через нос затруднено, сукровичные выделения из носа, иногда плёнки на его слизистой; голос становится сдавленным с гнусавым оттенком. Изо рта периодически появляется сладковато-приторный запах. Увеличиваются все группы шейных лимфатических узлов, которые образуют конгломерат, эластичный и болезненный, с отёком шеи (видно при осмотре больного). Цвет кожных покровов не изменён, надавливание безболезненное, не оставляет ямок. При токсической дифтерии I степени отёк шейной клетчатки достигает середины шеи; при токсической дифтерии II степени — отёк до ключицы; при III степени — отёк клетчатки ниже ключицы.
Гипертоксическая и геморрагическая формы
Наиболее тяжёлыми являются гипертоксические и геморрагические формы дифтерии.
При гипертоксической форме резко выражены симптомы интоксикации. Наблюдаются гипертермия, бессознательное состояние, коллапс, судороги. В зеве обширные налёты и отёк. Течение болезни стремительное. Летальный исход наступает на 2—3-й день болезни при нарастании сердечно-сосудистой недостаточности.
Геморрагическая форма дифтерии отличается множественной геморрагической сыпью с обширными кровоизлияниями, кровотечением из носа, дёсен, желудочно-кишечного тракта. В ротоглотке дифтерические налёты пропитаны кровью.
Развитие этих тяжёлых форм наблюдается при запоздалой диагностике и позднем введении противодифтерийной сыворотки. Без её применения выздоровление наступает лишь при локализованной форме дифтерии, но в этом случае, как правило, развиваются типичные осложнения: миокардит, периферические параличи. При раннем введении сыворотки симптомы интоксикации исчезают быстро, налёты в зеве отторгаются к 6—8-му дню.
Дифтерия других локализаций
Кроме зева, дифтерия может поражать слизистые оболочки носа, глаз, половых органов, а также раневые поверхности. Токсигенные
Лечение.
Лечение дифтерии проводится только в условиях стационара (в больнице). Госпитализация обязательна для всех больных, а также больных с подозрением на дифтерию и бактерионосителей.
Главным в лечении всех форм дифтерии (кроме бактерионосительства) является введение антитоксической противодифтерийной сыворотки (ПДС), которая подавляет дифтерийный токсин. Антибиотики не оказывают существенного действия на возбудителя дифтерии.
Осложнения
Осложнения дифтерии связаны с повреждением нервных и других клеток крайне ядовитым дифтерийным токсином.
Миокардиты, нарушения работы нервной системы, которые обычно проявляются в виде параличей. Чаще всего дифтерия осложняется параличами мягкого нёба, голосовых связок, мышц шеи, дыхательных путей и конечностей. Из-за паралича дыхательных путей может наступить асфиксия (при крупе), провоцирующая летальный исход.
Иммунитет
После перенесённого заболевания формируется нестойкий иммунитет, и приблизительно через 10-11 лет человек может заболеть вновь. Повторное заболевание носит нетяжёлый характер и переносится легче.
Профилактика
Основное значение в борьбе с дифтерией имеет активная плановая вакцинация населения вакцинами, содержащими адсорбированный дифтерийный анатоксин (АКДС-вакцина, АКДС-анатоксин, АДС—М-анатоксин), которая проводится в соответствии с календарём профилактических прививок; это позволяет создать длительный и напряжённый антитоксический иммунитет.
Большую роль в предупреждении распространения инфекции играют раннее выявление больных дифтерией, в том числе лёгкими и стёртыми формами, путём активного наблюдения и раннего бактериологического обследования больных ангиной, паратонзиллярным абсцессом, острым паратонзиллярным абсцессом; выявление носителей токсигенных штаммов коринебактерий дифтерии в очагах инфекции и при обследовании коллективов риска.
Больные и носители токсигенных коринебактерий подлежат изоляции и лечению (санации) в условиях стационара.
Дифтерия и ее профилактика
Казалось бы совсем недавно страна оправилась от последней вспышки дифтерии, но за 30 прошедших лет стало казаться, что ее никогда не было и уже не будет.
Редко сейчас встретишь молодого врача, который видел бы больного дифтерией, а все больше родителей отказываются вакцинировать детей: если болезни нет, то зачем прививаться?
И так из года в год число непривитых людей растет, и дифтерия превращается в часовую бомбу, и когда сработает механизм, никто не знает. Но зато мы примерно знаем о последствиях, для этого достаточно заглянуть в историю: десятки тысяч заболевших и тысячи смертей. Одни только устаревшие названия дифтерии — «петля палача», «злокачественная ангина», «смертельная язва глотки» — говорят о том, что просто не будет.
Что же нужно знать родителям, чтобы не пропустить это опасное инфекционное заболевание у себя и своих детей?
1. Дифтерия может передаваться контактно-бытовым и пищевым путями, но чаще всего — воздушно-капельным от больного человека, либо от здорового бактерионосителя. Что это значит? Это значит, что человек может быть абсолютно здоров, не иметь никаких симптомов, но при этом быть носителем дифтерийной палочки и заражать окружающих.
Дифтерия может передаваться контактно-бытовым и пищевым путями, но чаще всего — воздушно-капельным от больного человека, либо от здорового бактерионосителя. Что это значит? Это значит, что человек может быть абсолютно здоров, не иметь никаких симптомов, но при этом быть носителем дифтерийной палочки и заражать окружающих.
2. Бытует заблуждение, что опасность для человека представляет сама дифтерийная палочка, на самом деле все немного иначе: наибольшую опасность представляет токсин, который она вырабатывает. Он легко попадает в кровь, а затем – в сердце, почки, нервные ткани. Поражение этих органов может привести к смерти.
3. Первые симптомы заболевания дифтерией очень сходны с признаками ОРВИ: незначительно повышается температура, часто не выше 38 °С, появляется небольшая боль в горле. Родителей должно насторожить то, что насморк у ребенка отсутствует. Чуть позже в горле, чаще всего на миндалинах, появляется бело-серый налет, ребенок может жаловаться на осиплость голоса и затрудненное дыхание.
4. Иногда родители симптомы дифтерии принимают за ангину и начинают самостоятельное лечение на дому. Это подчас приводит к неприятным последствиям, которых можно избежать, если знать основные отличия между этими заболеваниями:
— миндалины при дифтерии покрыты пленкой белого цвета, а при ангине красные, воспаленные, иногда с желтоватым налетом или гноем.
— при дифтерии в воспалительный процесс вовлекается небо, а при ангине поражаются только миндалины.
— сильные боли при глотании характерны для ангины, но при дифтерии боль слабовыраженная, а больной чувствует дискомфорт.
5. У человека, который переболел дифтерией, пожизненный иммунитет, как при многих других инфекционных заболеваниях, не формируется. После заболевания остается нестойкий иммунитет, который не защищает от повторного заражения. Но есть и хорошая новость, как правило, при развитии дифтерии во второй раз болезнь протекает в легкой форме.
6. Только антибиотики не помогут, и на это есть причина! Как мы уже говорили выше, само заболевание вызывает не бактерия, а токсин, который она вырабатывает. Токсин, по сути, тот же яд, просто образуется он внутри организма. И к счастью для человечества противоядие нашлось! Дифтерию можно вылечить сывороткой, но вводить ее нужно не позднее 5-го дня от начала заболевания, а лучше всего в максимально короткие сроки. Вот почему так важно своевременно обращаться за медицинской помощью и не заниматься самолечением.
Токсин, по сути, тот же яд, просто образуется он внутри организма. И к счастью для человечества противоядие нашлось! Дифтерию можно вылечить сывороткой, но вводить ее нужно не позднее 5-го дня от начала заболевания, а лучше всего в максимально короткие сроки. Вот почему так важно своевременно обращаться за медицинской помощью и не заниматься самолечением.
7. Самый эффективный метод профилактики дифтерии – это вакцинация. В настоящее время существует несколько вакцин — АКДС, АДС-М, АДС, АД-М, все они содержат адсорбированный дифтерийный анатоксин – инактивированный токсин, к которому вырабатывается иммунитет. Дети прививаются по схеме 3 — 4,5 — 6 месяцев, первая ревакцинация проводится в 18 месяцев, вторая — в 6-7 лет, третья — в 14 лет. К сожалению, этот иммунитет, как и приобретенный в результате заболевания, нестойкий, однако он сохраняется гораздо дольше – около 10 лет. Именно поэтому взрослым рекомендовано проводить ревакцинацию каждые 10 лет.
Теперь, когда вы вооружены знаниями об этом опасном и иногда коварном заболевании, вы понимаете, насколько важно вовремя обратиться за медицинской помощью и как необходимо проведение вакцинации от дифтерии не только детей, но и взрослых. Берегите свое здоровье и здоровье ваших детей!
Берегите свое здоровье и здоровье ваших детей!
Дифтерия — симптомы, лечение, протекание
Общие сведения
Дифтерия — инфекционное заболевание, известное очень давно, вызываемое бактерией Corynebacterium diphtheriae (бацилла Лёффлера).
Дифтерия чаще всего поражает ротоглотку, но нередко затрагивает гортань, бронхи, кожу и другие органы. Инфекция передаётся воздушно-капельным путём от больного человека к здоровому. Возможен контактно-бытовой путь передачи заболевания, особенно в жарких странах, где часты кожные формы проявления.
Тяжесть протекания дифтерии обусловлена крайне ядовитым токсином, который выделяет дифтерийная палочка. Именно дифтерийный токсин, поражающий нервную, сердечно-сосудистую и выделительную системы, представляет главную опасность для здоровья и жизни. Если дифтерия поражает ротоглотку, то помимо тяжёлой интоксикации возможно развитие крупа – удушья, развивающегося при непроходимости дыхательных путей из-за развивающегося отека и механической обтурации (закупорки) их дифтерийной плёнкой. Современная медицина выделяет несколько видов дифтерии. Это дифтерия носа, глаз, зева, гортани, кожи, раны, а также половых органов. Бывают случаи, когда данное инфекционное заболевание захватывает сразу несколько зон человеческого организма. Наиболее опасны для окружающих люди, страдающие дифтерией зева, носа и гортани, интенсивно выделяющие инфекцию в окружающую среду с выдыхаемым воздухом.
Современная медицина выделяет несколько видов дифтерии. Это дифтерия носа, глаз, зева, гортани, кожи, раны, а также половых органов. Бывают случаи, когда данное инфекционное заболевание захватывает сразу несколько зон человеческого организма. Наиболее опасны для окружающих люди, страдающие дифтерией зева, носа и гортани, интенсивно выделяющие инфекцию в окружающую среду с выдыхаемым воздухом.
Вероятность заболеть
Опустошительные эпидемии дифтерии, жертвами которых, главным образом, являются дети, описаны во многих странах на протяжении всей истории. В странах с низким уровнем охвата прививками дифтерия по-прежнему является значительной проблемой для здоровья детей. Там, где уровень охвата прививками высокий, а естественный бустерный эффект незначительный (что наблюдается в большинстве промышленно развитых стран), значительная часть взрослого населения постепенно становится восприимчивой к дифтерии в результате снижения иммунитета.
Симптомы
Самой частой формой дифтерии (90-95 % всех случаев) является дифтерия ротоглотки. При локализованной форме налёты образуются только на миндалинах. Симптомы дифтерии выражаются в виде слабой интоксикации, температуры до 38-390С, головной болью, недомоганием, незначительными болями при глотании. Наиболее типична плёнчатая (сплошная) форма дифтерии, при которой плёнка с очерченными краями покрывает всю миндалину, трудно снимается шпателем; при попытке её снятия поверхность миндалины кровоточит; плёнка плотная; лимфатические узлы мало болезненны, подвижны.
При локализованной форме налёты образуются только на миндалинах. Симптомы дифтерии выражаются в виде слабой интоксикации, температуры до 38-390С, головной болью, недомоганием, незначительными болями при глотании. Наиболее типична плёнчатая (сплошная) форма дифтерии, при которой плёнка с очерченными краями покрывает всю миндалину, трудно снимается шпателем; при попытке её снятия поверхность миндалины кровоточит; плёнка плотная; лимфатические узлы мало болезненны, подвижны.
Осложнения после перенесенного заболевания
Серьезность дифтерии определяется опасными осложнениями. Токсин может вызывать инфекционно-токсический шок (комплексный патологический сдвиг деятельности всех жизненно важных систем организма), миокардит (воспаление сердечной мышцы), множественные поражения нервных стволов, воспаление и дистрофию почечных канальцев и др.
Чаще всего дифтерия протекает с осложнением в виде паралича мягкого неба, голосовых связок, мышц шеи, дыхательных путей и конечностей. Из-за паралича дыхательных путей может наступить асфиксия (при крупе), провоцирующая летальный исход.
Из-за паралича дыхательных путей может наступить асфиксия (при крупе), провоцирующая летальный исход.
При локализированной форме дифтерии зева осложнения возникают в 5-20 % случаев; при более серьезных формах заболевания процент развития осложнений значительно увеличивается. Чем сложнее клиническая форма дифтерии, тем быстрее осложнения проявляются у больного.
Раньше всех страдает сердце: в конце 1-й – на 2-й неделе болезни возникает миокардит (воспаление сердечной мышцы), что является самой частой причиной смерти. Воспаление почек происходит в наиболее острый период болезни. Нервная система поражается как при клинических проявлениях дифтерии, так и спустя 2-3 месяца после выздоровления
Типичное осложнение дифтерии – периферические параличи, они могут быть ранними и поздними. Ранние параличи появляются в остром периоде заболевания, в процесс вовлекаются преимущественно черепные нервы. При этом голос становится гнусавым, больной поперхивается во время еды, жидкая пища выливается через нос, нёбная занавеска неподвижно свисает. При параличе аккомодации больной не может различать мелкие предметы на близком расстоянии, читать, становится дальнозорким. Возможны косоглазие, птоз, паралич лицевого нерва.
При параличе аккомодации больной не может различать мелкие предметы на близком расстоянии, читать, становится дальнозорким. Возможны косоглазие, птоз, паралич лицевого нерва.
Смертность
До получения противодифтерийной антитоксической сыворотки летальность от дифтерии достигала 50-60%. После появления антитоксической сыворотки началось прогрессивное последовательное снижение летальности: 20% – у взрослых и 10% – у детей. Вслед за введением активной иммунизации заболеваемость стала быстро снижаться, дифтерия в смертности детского населения почти перестала играть роль.
Лечение
Лечение дифтерии проводится только в условиях стационара. Госпитализация обязательна для всех больных, а также больных с подозрением на дифтерию и бактерионосителей. Антибиотики (пенициллин или эритромицин) не оказывают влияния на вызванные экзотоксином поражения, но ограничивают дальнейший рост бактерий и продолжительность носительства возбудителя дифтерии, которое нередко продолжается даже после клинического выздоровления. Главным в лечении всех форм дифтерии (кроме бактерионосительства) является введение антитоксической противодифтерийной сыворотки (ПДС), которая подавляет дифтерийный токсин. Доза противодифтерийной сыворотки определяется тяжестью болезни. При подозрении на локализованную форму можно отсрочить введение сыворотки до уточнения диагноза. Если же врач подозревает токсическую форму дифтерии, то лечение сывороткой должно быть начато немедленно.
Главным в лечении всех форм дифтерии (кроме бактерионосительства) является введение антитоксической противодифтерийной сыворотки (ПДС), которая подавляет дифтерийный токсин. Доза противодифтерийной сыворотки определяется тяжестью болезни. При подозрении на локализованную форму можно отсрочить введение сыворотки до уточнения диагноза. Если же врач подозревает токсическую форму дифтерии, то лечение сывороткой должно быть начато немедленно.
К сожалению, заболевание дифтерией не всегда создает защитный иммунитет. Поэтому лица, выздоравливающие от дифтерии, в процессе поправки должны завершить активную иммунизацию дифтерийным анатоксином.
Эффективность вакцинации
Дифтерийный анатоксин в комбинации с вакцинами против столбняка и коклюша (АцКДС) использовался в рамках Расширенной программы иммунизации ВОЗ (РПИ) с момента ее создания в 1974 году. В течение периода 1980-2000 гг. общее число зарегистрированных случаев дифтерии было снижено более чем на 90%. Введение в 1994 г. массовой иммунизации населения России против дифтерии с повторной ревакцинацией взрослых в 2003-2004 гг. позволило обеспечить достаточную специфическую защиту населения от этой инфекции. Это, в совокупности с многолетним надзором, привело к снижению заболеваемости дифтерией в России с 26,8 в 1994 г. до 0,01 на 100 тыс. населения в 2009-2011 гг. Эффективность современных вакцин составляет 95%. Всемирной организацией здравоохранения вакцинация рекомендована для всех без исключения стран мира.
массовой иммунизации населения России против дифтерии с повторной ревакцинацией взрослых в 2003-2004 гг. позволило обеспечить достаточную специфическую защиту населения от этой инфекции. Это, в совокупности с многолетним надзором, привело к снижению заболеваемости дифтерией в России с 26,8 в 1994 г. до 0,01 на 100 тыс. населения в 2009-2011 гг. Эффективность современных вакцин составляет 95%. Всемирной организацией здравоохранения вакцинация рекомендована для всех без исключения стран мира.
Вакцины
Основное значение в борьбе с дифтерией имеет активная плановая вакцинация населения прививками, содержащими адсорбированный дифтерийный анатоксин (комбинированные вакцины: АКДС, Бубо-Кок, Бубо-М, «Тетраксим», «Пентаксим», «Инфанрикс», «Инфанрикс Гекса»; анатоксины: АДС, АДС-М, АД-М), которая проводится в соответствии с календарём профилактических прививок. Это позволяет создать длительный и антитоксический иммунитет.
Подробнее о вакцинах
Последние эпидемии
До начала XX века дифтерия ежегодно уносила тысячи детских жизней, а медицина была бессильна облегчить их страдания и спасти от тяжелой агонии.
Перелом с начала 60-х годов связан с внедрением массовой вакцинации против дифтерии. Успехи породили недопустимое благодушие, которое привело к снижению охвата прививками в 80-е годы. Результат – медленное, но характерное для дифтерии нарастание числа случаев. Все это закончилось небывалой эпидемией с заболеваемостью 25 на 100 000 населения в 1994-95 гг., в ходе которой в СНГ заболело 120 000 человек и умерло более 6 000.
Исторические сведения и интересные факты
Уже в первом веке нашей эры можно встретить упоминание о дифтерии, называемой тогда «петля удавленника» или «смертельная язва глотки». Первую же прививку сделал и применил на человеке Эмиль Беринг. 26 декабря 1891 года он спас жизнь больному ребенку, сделав ему первую прививку от дифтерии. Кстати, первая прививка была сделана из сыворотки переболевшей дифтерией морской свинки. Да и все предыдущие исследования проводились именно на этих животных. После этого Эмиль Ру стал делать прививку для масштабного применения не из сыворотки морских свинок, а использовал кровь иммунизированных лошадей. Благодаря этой прививке летальность от дифтерии упала до 1%. Используемый же теперь дифтерийный анатоксин был открыт только в 1923 году Гастоном Рамоном, который по образованию был биологом и ветеринаром.
Благодаря этой прививке летальность от дифтерии упала до 1%. Используемый же теперь дифтерийный анатоксин был открыт только в 1923 году Гастоном Рамоном, который по образованию был биологом и ветеринаром.
Диагностика дифтерийной инфекции
Дифтерия (дифтерийная инфекция) — острое инфекционное, бактериальное заболевание. Возбудителем является палочковидная бактерия вида Corynebacterium, которую еще называют дифтерийная палочка или бацилла Лёффлера по имени первооткрывателя.
Болезнь передается воздушно-капельным и контактно-бытовым путем. Преимущественно поражает ротоглотку, чуть реже нос, верхние дыхательные пути. Может затрагивать глаза, кожу и половые органы. В России проводится вакцинация от дифтерии начиная с 3-х месячного возраста, поэтому случаи заболевания достаточно редки. Согласно данным ВОЗ в мире получают три рекомендуемые дозы 86% детей, в результате чего формируется стойкий пожизненный иммунитет.
Источником болезни является инфицированный человек: больной или носитель патогенного штамма. Возбудитель выделяется из организма в период выздоровления достаточно долго: от 15 дней до 3 месяцев. Путь передачи ― аэрозольный, чаще заражение происходит воздушно-капельным путем, реже контактно-бытовым или воздушно-пылевым путем. Палочка может оставаться активной на использованной больным посуде, полотенцах. Способна размножаться в продуктах питания: готовых блюдах, мясе, молоке, сыре.
Бактерия обладает устойчивостью ко внешней среде, сохраняет жизнеспособность на протяжении 2 месяцев. На гладких поверхностях долго не задерживается, ее можно обнаружить на мягких игрушках, одежде, постельном белье, коврах, изделиях из шерсти. Дифтерийная палочка переносит холод, но погибает при температуре +60 С в течение 10 минут. Для нее также губительно ультрафиолетовое излучение (UV-лампы и прямые солнечные лучи), дезинфицирующие средства содержащие лизол или хлор.
Дифтерию разделяют на локализованную и распространенную формы.
По вариантам течение делят на 4 формы:
Дифтерия ротоглотки, которая подразделяется на:
-
Локализованную, характеризующуюся катаральным, островчатым и плёночным воспалением небных миндалин.
-
Распространенную, отличимую по наличию налета не только на миндалинах, но и на других слизистых ротоглотки.
-
Субтоксическую, гипертоксическую и токсическую с 1 по 3 степени.
-
Дифтерийный круп гортани, форма имеющая несколько вариантов течения:
-
Локализованный (затронута только гортань).
-
Распространенная, при котором поражена также трахея.
-
Нисходящий, затрагивающий также и бронхи.

-
Дифтерия, локализующаяся на других органах (участках тела): дифтерия носа, глаз, кожных покровов, половых органов.
-
Комбинированная форма заболевания, при которой затронуто несколько органов в не перечисленных выше комбинация.
В международной классификации болезней дифтерия имеет код A36.0 и несколько форм, исходя из локализации: дифтерия глотки, носоглотки, гортани, кожи, другая и неуточненная.
Симптомы дифтерии
К классической симптоматике, идентичной для большинства форм дифтерии, относятся:
-
повышение температуры;
-
выраженная слабость;
-
не сильный болевой синдром в горле;
-
затрудненное глотание;
-
плотно спаянный налет на миндалинах, чаще серо-белого цвета;
-
отек шеи и слизистых, увеличение небных миндалин и шейных лимфоузлов.

При некоторых формах заболевания симптомы могут отличаться. В 75% случаев диагностируют локализованную форму. В 90% случаев диагностируют дифтерию носоглотки. Начало острое с умеренной интоксикацией организма, сопровождается повышением температуры тела до +39 С. Лихорадка, длится не более 3 дней. Затем, появляется налет, который уплотняется, приобретает блеск. Любые попытки удалить его вызывают кровотечение.
Дифтерия ротоглотки
Локализованная форма выражается в появлении фибринозных (чаще) или рыхлых (реже) на небных миндалинах. Носоглотка воспаляется, лимфоузлы неравномерно увеличиваются. Воспаления могут быть двусторонними и односторонними. Температура, как правило, не повышается, интоксикация слабо выражена. Болевые ощущения незначительные.
Локализованная дифтерия ротоглотки одна из самых легких форм. При своевременном лечении не прогрессирует, быстро заканчивается выздоровлением. Если болезнь сопровождалась температурой, она проходит на 2 — 3 сутки, налет на миндалинах сходит через неделю.
Если болезнь сопровождалась температурой, она проходит на 2 — 3 сутки, налет на миндалинах сходит через неделю.
Распространенная форма встречается редко, отличается наличием налета не только на миндалинах, а также окружающих слизистых. Болевой синдром, интоксикация, увеличение лимфоузлов более сильные. Возникает боль в горле и области шеи, больному трудно глотать. Температура повышенная. Из основных симптомов:
-
Багровый цвет миндалин.
-
Налет на миндалинах, язычке и небных дужках.
-
Болезненная отечность подкожной клетчатки над лимфоузлами. Воспаление часто одностороннее.
Токсическая форма чаще диагностируется у взрослых. Для нее характерно бурное начало с повышением температуры до высоких значений. Среди основных симптомов:
-
Тахикардия.

-
Цианоз губ.
-
Артериальная гипотензия.
-
Интенсивная боль в горле, шее, животе.
На фоне интоксикации и высокой температуры возможны тошнота, рвота, бредовые состояния, возбуждение.
Наиболее тяжело протекает гипертоксическая форма дифтерийной инфекции. Она развивается на фоне ослабленного иммунитета, у лиц с хроническими болезнями. Например, алкоголизм, цирроз, СПИД, сахарный диабет. Заболевание опасно высокой вероятностью развития геморрагического синдрома с надпочечниковой недостаточностью. Без своевременной медицинской помощи человек может умереть в течение 1 — 2 дней.
Дифтерийный круп
-
Локализованная форма. Патологические процессы органичны слизистой гортани.
-
Распространенная форма.
 Инфицированы гортань и трахея.
Инфицированы гортань и трахея.
-
Нисходящая форма. Помимо гортани и трахеи, затронуты также бронхи.
Заболевание чаще отмечают у детей и младенцев. В последние годы возрастает число инфицированных среди взрослых. Иногда круп сопровождает дифтерию ротоглотки, в особо тяжелых формах патологические процессы могут проходить от ротовой полости до бронх. При этом, интоксикация слабо выражена, может возникнуть тошнота, повышение температуры. Инфекционный процесс сопровождается отечностью слизистых, воспалением дыхательных путей и голосовых складок гортани.
Заболевание проходит тремя последовательными стадиям:
-
Дисфоническая ― осиплость голоса, «лающий» кашель, дыхание шумное, кожные покровы бледны. Продолжительность стадии от 1 до 7 дней.
-
Стенотическая стадия (стеноз гортани) ― сужение просвета приводящее к затрудненному дыханию.

-
Асфиксическая ― сужение гортани достигает пика, иногда вовсе перекрывается, приводя к непроходимости дыхательных путей. До наступления этой стадии больной должен проходить лечение в стационаре. В противном случае гипоксия приведет к нарушению работы мозга, человек может умереть от удушья.
Выражается в наличие фибринозного или пленчатого налета на слизистой. Выделения серозно-гнойные, дыхание через нос затруднено. Кожные покровы вокруг ноздрей раздражены. Температура тела повышается редко, признаки интоксикации отсутствуют. Часто дифтерия носа сопровождает поражения ротовой полости.
Дифтерия глазКонъюнктивит, часто односторонний, характеризуется умеренными серозными выделениями. Воспаление конъюнктивы сопровождается отечностью век. Интоксикация слабо выражена, температура не поднимается.
Токсическая дифтерия глаз отличается сильной отечностью век, выраженными гнойными выделениями, острым началом. Почти всегда затрагивает оба глаза. Отмечается общая интоксикация организма, лихорадка.
Почти всегда затрагивает оба глаза. Отмечается общая интоксикация организма, лихорадка.
Сюда входят дифтерийные инфекции уха, кожи, половых органов. Диагностируются редко, связаны со способом заражения. Могут сопровождать дифтерию ротоглотки или носа. Пораженные участки отечны, ближайшие лимфоузлы воспалены. Наблюдаются фибринозные налеты, гнойные выделения.
Кожные инфекции развиваются в местах повреждения: царапины, раны. Дифтерия половых органов вызывает поражения крайней плоти у мужчин, слизистой влагалища у женщин. Могут быть поражены ближайшие ткани и слизистые. Мочеиспускание при воспаленной уретре вызывает боль, бывают гнойные выделения. Общее состояния больных удовлетворительное, без симптомов интоксикации и повышенной температуры. В отличие от других форм, заболевание может протекать медленно и долго.
Бессимптомное носительство
У лиц, ранее перенесших дифтерию, можно наблюдать бессимптомное носительство. Переход заболевания в эту стадию отмечают у людей с хроническими болезнями, в частности с хроническими воспалениями носоглотки. Сроки носительства индивидуальны.
Переход заболевания в эту стадию отмечают у людей с хроническими болезнями, в частности с хроническими воспалениями носоглотки. Сроки носительства индивидуальны.
Нередко клинический диагноз дифтерии ставят без проведения лабораторных анализов исходя из наличия серых пленок на слизистой горла. Это может иметь место в небольших населенных пунктах, при не сильном течении болезни у относительно здоровых взрослых. При обследовании детей, людей с хроническими заболеваниями, при неясной клинике рекомендовано проведение лабораторного исследования.
Наиболее часто выполняют следующие лабораторные тесты:
-
бактериологический анализ мазка;
-
серологический анализ;
-
ПЦР-анализ;
-
клинический анализ крови;
-
анализ на антитела.

Диагностика дифтерийного крупа осуществляется путем осмотра гортани через ларингоскоп. При развитии неврологических патологий требуется наблюдение невролога. При наличие признаков дифтерийного миокардита ― кардиолога, проведение УЗИ сердца и ЭКГ.
Краткое описание лабораторных исследований на дифтериюБактериологический анализ мазка является основным для постановки диагноза. Для исследования берут биоматериал, помещают его в питательную среду. Он находится в лаборатории 5 – 7 дней, за это время можно обнаружить не только развитие дифтерийной палочки, но и наличие у нее токсигенных свойств. Если выявлен токсигенный штамм, необходимо обследовать всех контактировавших с больным.
Дополнительно может быть проведена ПЦР-диагностика. Она не является обязательной для постановки диагноза. Забор материала происходит по аналогичной схеме. ПЦР позволяет выявить патоген и определить токсичен ли он.
Анализы на антитела (РПГА или ИФА) используются для постановки диагноза. Они занимают меньше времени, чем бактериологический анализ мазка, от 2 до 5 дней. Позволяют оценить уровень иммунитета (степень защищенность организма от инфекции). Поэтому эти анализы назначают людям, перед приемом на работу в лечебные учреждения и другие структуры, входящие в зону риска. Для исследования необходима венозная кровь.
Вне зависимости от метода диагностики РПГА или ИФА, результаты анализов расшифровывают одинаково. Маркер уровня равен 1:10 или 0,01 МЕ/мл. Если полученное значение ниже, значит шанс заболеть высок, необходима вакцинация.
Клинический анализ крови является вспомогательным методом, поскольку позволяет выявить лишь наличие бактериального воспаления. Результат нельзя использовать для дифференциальной диагностики, невозможно отличить дифтерию от ангины. Для проведения КАО используют венозную кровь.:max_bytes(150000):strip_icc()/c.diphteriae-5bcb8dfac9e77c005123bff1.jpg)
После выявления возбудителя или при подозрении на дифтерию клиницист обязан в течение 24 часов уведомить органы здравоохранения. Это необходимо для организации ведения дозы антитоксической противодифтерийной сыворотки (АПДС) инфицированному, а также для проведения эпидрасследования и выявления круга контактных лиц. На это мероприятие службе здравоохранения отводится 48 часов.
Дифтерию лечат врачи-инфекционисты, при осложненном течении заболевания могут привлекаться другие специалисты. Больных госпитализируют в инфекционные отделения клинических больниц. Амбулаторное лечение недопустимо, даже для бессимптомных носителей.
Терапия основывается на введении противодифтерийной антитоксической сыворотки. Среди дополнительных медикаментов:
-
При развитии вторичной инфекции назначают прием антибиотиков.
-
При токсических формах дифтерии назначают глюкозу, кокарбоксилазу, глюкокортикоидные препараты.
 При необходимости может быть назначен плазмаферез (фильтрация плазмы крови) для очищения от токсических веществ.
При необходимости может быть назначен плазмаферез (фильтрация плазмы крови) для очищения от токсических веществ.
-
При угрозе асфиксии осуществляется интубация трахеи (введение эндотрахеальной трубки). При обтурации пленками, нарушающими непроходимость верхних дыхательных путей проводят трахеостомию (создание соустья полости в трахеи хирургическим путем).
Дифтерия несет серьезную опасность своими осложнениями, как во время заболевания, так и после выздоровления. Чаще всего течение болезни осложняется токсическим нефрозом (острое поражение почек), недостаточностью надпочечников, инфекционно-токсическим шоком, приводящим к коме. Нередки воспаления миокардита и стволов нервной системы. Среди серьезных осложнений паралич дыхательных путей, он может привести к асфиксии.
Самая частая причина смерти ― миокардит, как правило, наступает в конце первой, начале второй недели с момента заражения. Поражение нервной системы может произойти как в период болезни, так и через несколько месяцев после выздоровления. Также наблюдаются ранние и поздние периферические параличи. Это приводит к следующим последствиям: гнусавость голоса, поперхивание во время приема пищи, вываливание ее через нос, паралич мимической мускулатуры лица, косоглазие, птоз, невозможность различать вблизи мелкие предметы.
Поражение нервной системы может произойти как в период болезни, так и через несколько месяцев после выздоровления. Также наблюдаются ранние и поздние периферические параличи. Это приводит к следующим последствиям: гнусавость голоса, поперхивание во время приема пищи, вываливание ее через нос, паралич мимической мускулатуры лица, косоглазие, птоз, невозможность различать вблизи мелкие предметы.
Наиболее благоприятен прогноз при локализованных, легких и средних формах. Но, при условии своевременно оказанного лечения с использованием АПДС. Наиболее опасны и менее благоприятны токсические формы заболевания, позднее начало лечения и развитие осложнений.
Профилактика дифтерии заключается в своевременной вакцинации. Первая прививка ставится детям в возрасте 3-х месяцев, последующие в срок 9 — 12 месяцев, затем 7 лет, 12 лет и подросткам в 16-летнем возрасте. Пройти вакцинацию могут и взрослые. Иммунитет после прививки и перенесенного заболевания сохраняется на протяжении 10 лет. Массовая вакцинация населения позволила снизить смертность от дифтерии до < 5%. Ранее она достигала 60%.
Иммунитет после прививки и перенесенного заболевания сохраняется на протяжении 10 лет. Массовая вакцинация населения позволила снизить смертность от дифтерии до < 5%. Ранее она достигала 60%.
Сдать анализы на дифтерию и другие бактериальные инфекции можно в одном из подразделений Северо-Западного центра доказательной медицины. Здесь для вас созданы все условия:
-
Доброжелательные сотрудники и отсутствие очередей.
-
Квалифицированные лаборанты и точное, современное оборудование.
-
Быстрая готовность результатов и несколько способов их получения.
Лабораторные терминалы и медицинские центры имеют удобное расположение для проезда на общественном транспорте и личном авто. Пройти исследование можно в Санкт-Петербурге и других городах ЛО, Великом Новгороде и Новгородское области, Калининграде и Пскове.
Профилактика дифтерии
Дифтерия
ДИФТЕРИЯ — (от греч. diphtherion — кожица, пленка) — острое инфекционное заболевание, протекающее с воспалением, сопровождающимся образованием плотных пленчатых налетов на месте внедрения возбудителя болезни и тяжелого общего отравления организма.
Вызывается дифтерия особым микробом (дифтерийной палочкой) — палочкой Лефлера (по имени немецкого ученого Лефлера, изучившего ее). Дифтерийная палочка довольно устойчива к холоду и высушиванию — на предметах, бывших в употреблении больного.
Источником дифтерийной инфекции в природе является больной дифтерией человек, выздоравливающий от дифтерии или бациллоноситель. Заболевший дифтерией может передавать инфекцию и в последние дни скрытого (инкубационного) периода болезни, в течение всего заболевания и в течение некоторого, иногда длительного, периода выздоровления.
При кашле, чихании, разговоре больного капельки слюны, слизи, мокроты, в которых содержатся микробы дифтерии, попадают в воздух (т. наз. капельная инфекция), а также на окружающие больного предметы (постель, белье, одежду, посуду, пищу и т. п.). При дыхании этим воздухом или при пользовании вещами могут заражаться здоровые люди.
наз. капельная инфекция), а также на окружающие больного предметы (постель, белье, одежду, посуду, пищу и т. п.). При дыхании этим воздухом или при пользовании вещами могут заражаться здоровые люди.
Нередко дифтерия передается и через окружающих больного лиц. Местом внедрения дифтерийных микробов при заражении дифтерией являются слизистые оболочки. Чаще всего наблюдается дифтерия зева, на втором месте по частоте стоит дифтерия гортани; встречается также дифтерия глаз, дифтерия раны и т.д. Дифтерийная палочка, размножаясь на месте внедрения, выделяет яд (токсин), разносящийся по лимфатической и кровеносной системе. Действием этого токсина и обусловлены в основном общие проявления дифтерии.
При дифтерии зева после инкубационного периода начинает медленно повышаться температура до 38,5—39°, появляется небольшая боль при глотании. В зеве появляется налет, распространяющийся в виде пленки на миндалины, а в некоторых случаях и на слизистую оболочку небных дужек, язычка, глотки, носоглотки, надгортанника; тогда отек окружающих тканей резко выражен, глотание сильно затруднено, налеты грязно-зеленого цвета; общетоксические явления наступают на 5-6-й день болезни. Могут появиться нарушение ритма сердцебиения, увеличение печени, нарушения со стороны нервной системы. Иногда общие явления тяжелой интоксикации выступают на первый план, и болезнь характеризуется быстрым нарастанием всех проявлений; часты носовые и носоглоточные кровотечения, с первых же дней болезни появляются резкая бледность, боли в животе, рвота, понос, нарастающее расстройство кровообращения (поражение сердечной мышцы и др.), падение температуры, явления коллапса.
Могут появиться нарушение ритма сердцебиения, увеличение печени, нарушения со стороны нервной системы. Иногда общие явления тяжелой интоксикации выступают на первый план, и болезнь характеризуется быстрым нарастанием всех проявлений; часты носовые и носоглоточные кровотечения, с первых же дней болезни появляются резкая бледность, боли в животе, рвота, понос, нарастающее расстройство кровообращения (поражение сердечной мышцы и др.), падение температуры, явления коллапса.
Профилактика дифтерии
Для предохранения детей от заболевания дифтерией проводят предохранительные прививки, для чего применяется дифтерийный анатоксин. В России прививки делаются в обязательном порядке всем здоровым детям в возрасте от 5—6 месяцев до 12 лет.
Взрослым ревакцинацию от дифтерии без ограничения возраста,
проводят каждые 10 лет.
Вакцинация проводится в каб. 117 (ул. Ленина,81) и в каб.№ 420 (ул. Труда,1) после консультации врача-терапевта или инфекциониста
117 (ул. Ленина,81) и в каб.№ 420 (ул. Труда,1) после консультации врача-терапевта или инфекциониста
Профилактика заболевания дифтерией
Дифтерия — острое инфекционное заболевание, протекающее с интоксикацией, развитием воспалительного процесса, сопровождающегося образованием фибринозной пленки в месте внедрения возбудителя.
Возбудитель заболевания — дифтерийная палочка, которая хорошо сохраняется в окружающей среде. Так, в воде и молоке она жизнеспособна 7 дней; на игрушках, белье, книгах, посуде — нескольких недель. Все дезинфицирующие средства (перекись водорода, хлорамин и т.п.) в обычных концентрациях убивают дифтерийную палочку; под действием прямых солнечных лучей она погибает через несколько часов.
Источником инфекции является больной человек
или носитель бактерии дифтерии. Ведущий путь передачи дифтерии — воздушно – капельный (при вдыхании бактерий от больного
или носителя дифтерии), реже – бытовой путь (через предметы, игрушки и т. д.).
д.).
Инкубационный (скрытый) период заболевания составляет от 2 до 10 дней.
Проявления дифтерии различны. Непродолжительная лихорадка, с подъемом температуры от 38 до 40С, слабость, головные боли, снижение аппетита, артериальная гипотензия. Изменения ротоглотки в виде налётов белого цвета, при попытке снятия налёта обнажается эрозивная поверхность. Дифтерия ротоглотки проявляется болью в горле, при токсических формах развивается отёк шеи и верхней половины грудной клетки, выраженная бледность кожи. При дифтерии дыхательных путей: грубый лающий кашель, одышка. При дифтерии носа: затруднение носового дыхания, кровянистое отделяемое из носовых ходов.
Боль в горле при глотании — ранний симптом дифтерии ротоглотки. В зеве
обнаруживается неяркое покраснение, отечность миндалин и небных дужек, на которых формируются белые или серовато-белые плотные
пленчатые налеты с перламутровым блеском.
Характерные симптомы заболевания: бледность кожи, грубый “лающий” кашель, хриплость голоса и затрудненное дыхание. Охриплость усиливается вплоть до полной потери голоса, развивается расстройство дыхания — оно становится слышным на расстоянии, возникают приступы удушья, ребенок синеет, мечется в кровати, быстро слабеет. При несвоевременном оказании медицинской помощи может наступить смерть.
Клиническая картина дифтерии у взрослых в настоящее время отличается значительным увеличением числа тяжелых, токсических форм, которые характеризуются теми же симптомами, что и у детей. Иногда единственным симптомом поражения гортани является осиплость голоса. Осложнения у взрослых могут развиться при любой форме дифтерии. Наиболее частым осложнением является миокардит (поражение миокарда — сердечной мышцы).
Любые формы дифтерии требуют строгой изоляции
больного и лечения только в условиях больницы.
Самой эффективной мерой профилактики дифтерии является иммунизация.
Вакцинация детей против дифтерии:
I | II | III |
3 месяца | 4,5 месяца | 6 месяцев |
Первая ревакцинация — 18 месяцев
Вторая ревакцинация — 7 лет
Третья ревакцинация — 14 лет
Прививка против дифтерии проводится одновременно с вакцинацией против коклюша и столбняка АКДС –вакциной (Адсорбированная коклюшно –дифтерийно – столбнячная вакцина), которая состоит из взвеси убитых коклюшных микробов и очищенных дифтерийного и столбнячного анатоксинов, адсорбированных (очищенных) на гидроксиде алюминия.
АКДС — комбинированные вакцины против дифтерии, столбняка и коклюша.
АДС — вакцины против дифтерии и столбняка применяющиеся при наличии тех
или иных противопоказаний к АКДС-вакцинам, включая перенесенный коклюш.
АДС-М — вакцины для профилактики дифтерии и столбняка у детей старше 6 лет и взрослых, со сниженным содержанием дифтерийного компонента.
АД-М — моновакцина для профилактики дифтерии.
Все компоненты АКДС-вакцин способны формировать иммунитет практически у 100% привитых.
АКДС вводятся внутримышечно, детям до 18 месяцев — в передне-наружную поверхность бедра, детям старше 18 месяцев — в дельтовидную мышцу (верхняя треть плеча). Введение вакцины в ягодичную мышц не желательно, поскольку ягодицы грудного ребенка имеют большую прослойку жировой ткани и препарат может попасть в жировую клетчатку.
Анатоксины (АДС, АДС-М и АД-М) детям дошкольного возраста вводят так же, как АКДС вакцину, а школьникам препарат можно вводить еще и подкожно в подлопаточную область.
Вакцинация взрослых.
Плановой иммунизации подлежат лица в возрасте 25 лет и старше, не получившие ревакцинации в
течение последних 10 лет. Повторные ревакцинации против дифтерии осуществляют каждые 10 лет.
Повторные ревакцинации против дифтерии осуществляют каждые 10 лет.
Если взрослые лица ранее не были привиты против дифтерии, не болели дифтерией и не были носителями токсигенных коринебактерий дифтерии, то они должны получить полный курс прививок (2 вакцинации с интервалом 45 дней и через 6 — 9 месяцев — ревакцинацию). Последующие ревакцинации им также проводят каждые 10 лет.
Взрослым, привитым или не привитым, переболевшим дифтерией в легкой форме, или носителям токсигенных коринебактерий дополнительную прививку против дифтерии не делают. Ревакцинацию им следует провести через 10 лет после заболевания или выявленного носительства.
Взрослым, перенесшим токсические формы дифтерии, независимо от полученных ранее прививок прививку против дифтерии
проводят не ранее чем через 6 месяцев после перенесенного заболевания двукратно с интервалом 45 дней. Последующие ревакцинации
делают каждые 10 лет.
При проведении противоэпидемических мероприятий в очаге дифтерии прививкам подлежат контактировавшие лица, не привитые или не имеющие защитного уровня дифтерийного антитоксина по результатам серологического обследования, а также лица, у которых с момента последней прививки против дифтерии прошло 10 лет и более.
Вакцина поставляется в лечебно-профилактические учреждения города Ижевска за счет федерального бюджета и для населения является бесплатной.
Дифтерия и кишечные инфекции
К кишечным инфекциям относятся дизентерия, брюшной тиф, паратифы А и Б, холера, гастроэнтерит, пищевые токсикоинфекции, вирусный гепатит А, вирусные диареи. Основными проявлениями заболевания кишечными инфекциями, на которые следует обращать внимание, являются слабость, вялость, плохой аппетит, диарея, рвота, боли в животе, может повыситься температура и появиться озноб.
Для всех этих заболеваний характерным является проникновение возбудителей через рот и размножение их в кишечнике человека, откуда они с выделениями вновь попадают во внешнюю среду: почву, воду, на различные предметы и продукты питания.
Возбудители кишечных инфекций обладают высокой устойчивостью во внешней среде, сохраняя свои болезнетворные свойства в течение от нескольких дней до нескольких недель, и даже месяцев. Еще более устойчивы во внешней среде патогенная кишечная палочка, возбудители брюшного тифа, вирусного гепатита, вирусы.
В пищевых продуктах возбудители кишечных инфекций не только сохраняются, но и активно размножаются, не меняя при этом внешнего вида и вкуса продукта.
Но при действии высокой температуры, например при кипячении, возбудители кишечных инфекций погибают.
Источником заражения кишечными инфекциями является человек – больной или бактерионоситель (практически здоровый человек, в организме которого находятся возбудители кишечных инфекций).
Восприимчивость людей к кишечным инфекциям довольно высокая. Особенно подвержены им дети. В условиях несоблюдения мер общественной и личной гигиены кишечные инфекции проявляют высокую контагиозность, могут быстро распространяться среди окружающих больного (бактерионосителя) лиц и вызывать массовые заболевания людей.
Наибольший подъем заболеваемости кишечными инфекциями наблюдается в летне-осенний период, что связано с выездами на отдых, потреблением овощей и фруктов, уличной торговлей скоропортящимися продуктами, нарушением водного режима и др. Возбудители острых кишечных инфекций могут находиться на различных предметных поверхностях, овощах, ягодах, фруктах. Заражение различных предметов и пищевых продуктов может произойти при загрязнении их руками, а также при неправильной транспортировке, хранении.
Опасность заражения кишечными инфекциями представляют продукты (блюда из них), употребляемые в холодном виде, без тепловой обработки, например, салаты, заливные, молоко и молочные продукты, мясные полуфабрикаты.
Одним из факторов заражения и распространения кишечных инфекций является вода. Опасность заражения кишечными инфекциями представляет употребление для питья, мытья посуды, рук, овощей и фруктов воды открытых водоемов, талой воды. Заражение может произойти при купании в открытых водоемах.
К заражению кишечными инфекциями может привести употребление воды из колодца, если колодец неправильно построен или неправильно используется (отсутствует глиняный замок, колодец находится вблизи уборных, жители берут воду индивидуальными ведрами, стирают белье и моют посуду в непосредственной близости от колодца).
Профилактика кишечных инфекций включает простые правила гигиены:
- обязательное тщательное мытье рук с мылом перед приготовлением, приемом пищи и после туалета;
- коротко стричь и содержать в чистоте ногти;
- воду для питья употреблять кипяченную, бутилированную или из питьевого фонтанчика с системой доочистки водопроводной воды;
- овощи и фрукты, в том числе цитрусовые и бананы употреблять только после мытья их чистой водой и ошпаривания кипятком;
- разливное молоко употреблять после кипячения;
- творог, приготовленный из сырого молока или развесной, лучше употреблять только в виде блюд с термической обработкой;
- все пищевые продукты следует хранить в чистой закрывающейся посуде;
- скоропортящиеся продукты сохранять в холодильниках в пределах допустимых сроков хранения;
- хлеб нужно носить из магазина в пакете отдельно от других продуктов;
- обязательны соблюдение чистоты в жилище, частое проветривание, ежедневное проведение влажной уборки;
- следует оберегать от мух пищевые продукты, сразу мыть грязную посуду;
- надо систематически опорожнять и мыть емкости для сбора для бытовых отходов;
- в целях борьбы с мухами следует защищать оконные проемы сеткой;
- купаться в открытых водоемах в летний период года можно только в специально отведенных местах;
- на вокзалах, в аэропортах, местах массового отдыха при питье бутилированной, газированной воды пользуйтесь одноразовым стаканчиком или индивидуальным поильником;
- при пользовании колодцем, брать воду из него только ведром общего пользования, а не личным.

При возникновении признаков кишечной инфекции следует немедленно обратиться за медицинской помощью к врачу, выполнять и соблюдать его назначения и рекомендации. Никакого самолечения, не принимать самостоятельно никаких лекарств, особенно антибиотиков! Можно давать обильное питье.
Несвоевременное обращение за медицинской помощью может отрицательно сказаться на здоровье и привести к заражению окружающих.
Corynebacterium diphtheriae — обзор
Естественная история, патогенез и патология
Corynebacterium diphtheriae — грамположительная, тонкая, неподвижная, не спорулирующая палочка. На основе морфологии и биохимических характеристик колонии выделяются четыре биотипа C. diphtheriae (gravis, mitis, intermediate и belfanti). Некоторые штаммы продуцируют мощный экзотоксин дифтерии. Прежде чем C. diphtheriae станет токсигенным, он должен быть лизогенизирован определенным бактериофагом. Коринебактериофаг несет структурный ген токсина ( tox ). Токсинпродуцирующие штаммы всех биотипов продуцируют идентичный дифтерийный экзотоксин [1]. Между биотипами не было продемонстрировано стойких различий в патогенности или тяжести заболевания. Токсигенные штаммы C. diphtheriae не являются инвазивными, но вызывают локализованное токсин-опосредованное заболевание у восприимчивых людей, колонизируя слизистую оболочку верхних дыхательных путей или кожные раны и язвы. В редких случаях могут быть инфицированы другие участки слизистой оболочки, например конъюнктива, ухо и влагалище.После вдыхания микроорганизмы размножаются в колонизированном месте и вызывают воспалительную реакцию в слизистой оболочке носоглотки, ротоглотки, гортани или трахеи. Воспаление характеризуется выраженной нейтрофильной инфильтрацией, закупоркой сосудов и интерстициальным отеком. Лизогенизированные организмы продуцируют дифтерийный токсин, который подавляет внутриклеточный синтез белка и вызывает местный эпителиальный некроз с густым фибринозно-гнойным экссудатом.
Коринебактериофаг несет структурный ген токсина ( tox ). Токсинпродуцирующие штаммы всех биотипов продуцируют идентичный дифтерийный экзотоксин [1]. Между биотипами не было продемонстрировано стойких различий в патогенности или тяжести заболевания. Токсигенные штаммы C. diphtheriae не являются инвазивными, но вызывают локализованное токсин-опосредованное заболевание у восприимчивых людей, колонизируя слизистую оболочку верхних дыхательных путей или кожные раны и язвы. В редких случаях могут быть инфицированы другие участки слизистой оболочки, например конъюнктива, ухо и влагалище.После вдыхания микроорганизмы размножаются в колонизированном месте и вызывают воспалительную реакцию в слизистой оболочке носоглотки, ротоглотки, гортани или трахеи. Воспаление характеризуется выраженной нейтрофильной инфильтрацией, закупоркой сосудов и интерстициальным отеком. Лизогенизированные организмы продуцируют дифтерийный токсин, который подавляет внутриклеточный синтез белка и вызывает местный эпителиальный некроз с густым фибринозно-гнойным экссудатом. Некротический мусор, экссудат, белые и красные кровяные тельца, фибрин и бактерии коагулируют, образуя грязно-серую и прилипшую псевдомембрану над слизистой оболочкой.Расширение псевдомембраны может привести к опасной для жизни обструкции дыхательных путей. Попытки удалить псевдомембрану обычно приводят к кровотечению на месте. При лечении или контроле инфекции мембрана может отслоиться от ложа слизистой оболочки сосудов и привести к кровотечению и удушью, или она может отхаркиваться. Токсин дифтерии может всасываться из очага инфекции в кровоток и переноситься в отдаленные места. Системная абсорбция увеличивается с расширением локального воспалительного процесса и увеличением псевдомембраны.В отсутствие циркулирующих нейтрализующих антител к дифтерийному токсину может произойти обширное опосредованное токсином повреждение органов-мишеней, особенно в сердце и периферической нервной ткани. Повреждение миокарда проявляется миокардитом, который характеризуется отеком, инфильтрацией мононуклеарных клеток и жировыми изменениями, а также очаговым некрозом миокарда и его проводящей системы.
Некротический мусор, экссудат, белые и красные кровяные тельца, фибрин и бактерии коагулируют, образуя грязно-серую и прилипшую псевдомембрану над слизистой оболочкой.Расширение псевдомембраны может привести к опасной для жизни обструкции дыхательных путей. Попытки удалить псевдомембрану обычно приводят к кровотечению на месте. При лечении или контроле инфекции мембрана может отслоиться от ложа слизистой оболочки сосудов и привести к кровотечению и удушью, или она может отхаркиваться. Токсин дифтерии может всасываться из очага инфекции в кровоток и переноситься в отдаленные места. Системная абсорбция увеличивается с расширением локального воспалительного процесса и увеличением псевдомембраны.В отсутствие циркулирующих нейтрализующих антител к дифтерийному токсину может произойти обширное опосредованное токсином повреждение органов-мишеней, особенно в сердце и периферической нервной ткани. Повреждение миокарда проявляется миокардитом, который характеризуется отеком, инфильтрацией мононуклеарных клеток и жировыми изменениями, а также очаговым некрозом миокарда и его проводящей системы. Полинейропатия возникает в результате дегенерации миелиновой оболочки и осевого цилиндра черепных или периферических нервов. Иногда острый некроз канальцев почек может привести к почечной недостаточности [4, 5].
Полинейропатия возникает в результате дегенерации миелиновой оболочки и осевого цилиндра черепных или периферических нервов. Иногда острый некроз канальцев почек может привести к почечной недостаточности [4, 5].
Инфекция, вызванная нетоксигенным C. diphtheriae , может быть связана с болью в горле без образования псевдомембран, но с инвазивным заболеванием. Бактериемия, эндокардит, аневризмы, остеомиелит и септический артрит были зарегистрированы среди групп наркоманов, алкоголиков, бездомных и австралийских аборигенов.
Corynebacterium diphtheriae and Diphtheria
Для поиска по всей книге введите термин или фразу в форму подПользовательский поиск
Дифтерия (страница 1)
В этой главе 4 страницы
© Кеннет Тодар, доктор философии
Дифтерия
Коринебактерии дифтерии
Коринебактерии грамположительные, аэробные, неподвижные, палочковидные. бактерии, классифицируемые как актинобактерии.Коринебактерии филогенетически связаны с микобактериями и актиномицеты. Они делают не образуют споры или разветвляются, как актиномицеты, но они имеют свойство образовывать нерегулярные, булавовидные или V-образные формы при нормальном росте. Они проходят щелчок движения сразу после деления клеток, что приводит их к характерные формы, напоминающие китайские буквы или палисады.
бактерии, классифицируемые как актинобактерии.Коринебактерии филогенетически связаны с микобактериями и актиномицеты. Они делают не образуют споры или разветвляются, как актиномицеты, но они имеют свойство образовывать нерегулярные, булавовидные или V-образные формы при нормальном росте. Они проходят щелчок движения сразу после деления клеток, что приводит их к характерные формы, напоминающие китайские буквы или палисады.
Род Corynebacterium состоит из разнообразной группы бактерии включая патогены животных и растений, а также сапрофиты. Немного коринебактерии являются частью нормальной флоры человека, находя подходящую нишу в практически каждый анатомический участок, особенно кожа и ноздри. Самый известный и наиболее широко изученным видом является Коринебактерии diphtheriae , возбудитель болезни дифтерия.
Рисунок 1. Окрашенная Corynebacterium клетки. «Решетчатый» вид обусловлен наличием полифосфатов. включения называют метахроматическими гранулами. Обратите внимание на характеристику Расположение ячеек «китайско-буквенное».
«Решетчатый» вид обусловлен наличием полифосфатов. включения называют метахроматическими гранулами. Обратите внимание на характеристику Расположение ячеек «китайско-буквенное».
Дифтерия — верхняя заболевание дыхательных путей, характеризующееся болью в горле, низкой температурой и адгезивная мембрана (называемая псевдомембрана на миндалинах, глотке и / или полости носа.Токсин дифтерии продуцируется C. diphtheriae , может вызывать миокардит, полиневрит и другие системные токсические эффекты. Более легкая форма дифтерии может быть ограничивается кожей.
Дифтерия — заразное заболевание, распространяемое прямой физический контакт или вдыхание аэрозольных выделений инфицированных лиц. Когда-то довольно распространенная дифтерия в значительной степени искоренена в развитых странах благодаря широкому использованию вакцины АКДС.За например, в США с 1980 по 2004 г. было зарегистрировано 57 случаи дифтерии. Тем не менее, это остается проблемой во всем мире. (В 2006 г. в ВОЗ было сообщено о 3978 случаях) несмотря на прилагаемые усилия для достижения глобального охвата вакцинацией.
было зарегистрировано 57 случаи дифтерии. Тем не менее, это остается проблемой во всем мире. (В 2006 г. в ВОЗ было сообщено о 3978 случаях) несмотря на прилагаемые усилия для достижения глобального охвата вакцинацией.
Дифтерия — серьезное заболевание, летальность которого составляет от 5% до 10%. У детей до 5 лет и взрослых старше 40 лет летальность ставка может достигать 20%.Вспышки, хотя и очень редкие, все же происходят. во всем мире, даже в развитых странах. После распада бывшего Советского Союза в конце 1980-х, уровень вакцинации в составляющая страны упали настолько низко, что наблюдался всплеск заболеваемости дифтерией. В 1991 г. в СССР было 2 000 случаев дифтерии. К 1998 г., по данным По оценкам Красного Креста, в Содружество Независимых Государств, 5000 человек погибли.
Рисунок 2. Это рисунок показывает зарегистрированную глобальную заболеваемость дифтерией в период с 1980 г. и 2006 г. В целом, по мере увеличения охвата прививками АКДС, снизилась заболеваемость дифтерией. Однако обратите внимание на всплеск между 1993 и 1997 годами, что связано с падением охвата вакцинацией в новых независимых государствах бывшего Советского Союза, как объясняется в текст выше.ВОЗ.
и 2006 г. В целом, по мере увеличения охвата прививками АКДС, снизилась заболеваемость дифтерией. Однако обратите внимание на всплеск между 1993 и 1997 годами, что связано с падением охвата вакцинацией в новых независимых государствах бывшего Советского Союза, как объясняется в текст выше.ВОЗ.
История и предыстория
Ни одна бактериальная болезнь человека не прошла столь успешно учился на дифтерию. Этиология, путь передачи, патогенетический механизм и молекулярный основы структуры, функции и действия экзотоксина были четко определены. учредил. Следовательно, высокоэффективные методы лечения и профилактики дифтерия были разработаны.
Изучение Corynebacterium diphtheriae тщательно отслеживает разработка медицинской микробиологии, иммунологии и молекулярной биологии. Много взносы к этим областям, а также к нашему пониманию бактерий-хозяев взаимодействия, были сделаны исследования дифтерии и токсина дифтерии. Некоторые из основные вехи на этом пути представлены ниже.
Некоторые из основные вехи на этом пути представлены ниже.
Гиппократ дал первое клиническое описание дифтерии в 4 век до н. э. Также есть упоминания о болезни в древний Сирия и Египет.
В XVII веке смертоносные эпидемии дифтерии охватили Европу; в Испании болезнь получила название «Эль гаратилло» (душитель), в Италия и Сицилия как «болезнь пищевода».
В 18 веке болезнь достигла американских колоний, где он достиг масштабов эпидемии около 1735 года. Часто умирали целыми семьями. из болезнь через несколько недель.
Бактерия, вызывающая дифтерию, была впервые описана Клебсом в 1883 г., а в 1884 г. культивировал Лёффлер, применивший метод Коха. постулаты и правильно идентифицировали Corynebacterium diphtheriae как агент болезни.
В 1884 году Леффлер пришел к выводу, что C. diphtheriae производит растворимый токсина, и тем самым предоставили первое описание бактериального экзотоксин.
В 1888 году Ру и Йерсен продемонстрировали присутствие токсина в то бесклеточная культуральная жидкость C. diphtheriae , которая при инъекции в подходящие лабораторные животные, вызвавшие системное проявление дифтерии.
Два года спустя фон Берингу и Китасато удалось иммунизировать Гвинея свиней с термически ослабленной формой токсина и продемонстрировали, что сыворотки иммунизированных животных содержали антитоксин, способный защищать другие восприимчивые животные к болезни. Этот модифицированный токсин был подходит для иммунизации животных для получения антитоксина, но было обнаружено к вызывают серьезные местные реакции у людей и не могут использоваться в качестве вакцина.
В 1909 году Теобальд Смит в США продемонстрировал, что дифтерия токсин которые были нейтрализованы антитоксином (образуя Toxin-Anti-Toxin комплекс, ТАТ ) оставался иммуногенным и устранял местные реакции, наблюдаемые в модифицированный токсин. В течение нескольких лет, начиная примерно с 1910 г., ТАТ использовалась для активных иммунизация против дифтерии.ТАТ имел две нежелательные характеристики как вакцина. Во-первых, использованный токсин был высокотоксичным, и введенное количество могло привести к фатальной токсемии, если токсин не был полностью нейтрализован антитоксин. Во-вторых, смесь антитоксинов представляла собой лошадиную сыворотку, компоненты которой имеет тенденцию вызывать аллергию и повышать чувствительность людей к сыворотке.
В течение нескольких лет, начиная примерно с 1910 г., ТАТ использовалась для активных иммунизация против дифтерии.ТАТ имел две нежелательные характеристики как вакцина. Во-первых, использованный токсин был высокотоксичным, и введенное количество могло привести к фатальной токсемии, если токсин не был полностью нейтрализован антитоксин. Во-вторых, смесь антитоксинов представляла собой лошадиную сыворотку, компоненты которой имеет тенденцию вызывать аллергию и повышать чувствительность людей к сыворотке.
В 1913 году Шик разработал кожную пробу как средство определения восприимчивость или иммунитет к дифтерии у людей.Токсин дифтерии вызывает воспалительный реакция при внутрикожном введении очень малых количеств. В Шик Тест включает в себя введение очень небольшой дозы токсина под кожу. из предплечье и оценка места инъекции через 48 часов. А положительный тест (воспалительная реакция) указывает на предрасположенность (отсутствие иммунитета). А отрицательный тест (реакции нет) свидетельствует об иммунитете (антитела нейтрализуют токсин).
А отрицательный тест (реакции нет) свидетельствует об иммунитете (антитела нейтрализуют токсин).
В 1924 году Рамон продемонстрировал превращение дифтерийного токсина в это нетоксичный, но антигенный эквивалент ( анатоксина ) при лечении формальдегид. Он предоставил человечеству одну из самых безопасных и надежных вакцин. время, анатоксин дифтерии.
В 1951 году Фримен сделал замечательное открытие, что патогенный (токсигенный) штаммы C. diphtheriae являются лизогенные (т. е. заражены умеренным Бета-фаг), тогда как нелизогенизированные штаммы авирулентны. Впоследствии Это было показано, что ген продукции токсина расположен на ДНК то Бета-фаг.
В начале 1960-х Паппенгеймер и его группа в Гарварде провели эксперименты по механизму действия дифтерийного токсина. Они изучили действие токсина в культурах клеток HeLa и в бесклеточных систем, и пришел к выводу, что токсин ингибирует синтез белка блокировка перенос аминокислот от тРНК к растущей полипептидной цепи на рибосоме. Они обнаружили, что это действие токсина могло быть нейтрализован путем предварительного лечения дифтерийным антитоксином.
Они обнаружили, что это действие токсина могло быть нейтрализован путем предварительного лечения дифтерийным антитоксином.
Впоследствии был показан точный механизм действия токсина, и токсин стал классической моделью АДФ-рибозилирования. бактериальный экзотоксин.
Дифтерия в США
На рубеже веков в США дифтерия был общий, встречались в основном у детей и были одной из основных причин смерть у младенцев и детей.В 1920-х годах, когда были впервые собраны данные, было приблизительно 150 000 случаев и 13 000 о случаях смерти сообщается ежегодно. После введения иммунизации против дифтерии количество заболевших постепенно упало примерно до 19 000 в 1945 году. дифтерия иммунизация получила широкое распространение в конце 1940-х годов, более быстрое снижаться по количеству заболевших и наступивших летальных исходов.
С 1970 по 1979 год в среднем 196 случаев в год сообщил. Семнадцать вспышки 15 или более случаев произошли в Соединенных Штатах между 1959 г. и 1980 г., но с 1980 г. их не было. В 1980–1995 гг. всего 41 случай респираторной дифтерии сообщалось; из них четыре (10%) закончились смертельным исходом, и все произошли в непривитые дети.
Семнадцать вспышки 15 или более случаев произошли в Соединенных Штатах между 1959 г. и 1980 г., но с 1980 г. их не было. В 1980–1995 гг. всего 41 случай респираторной дифтерии сообщалось; из них четыре (10%) закончились смертельным исходом, и все произошли в непривитые дети.
С 1988 г. Пять из шести дифтерий с положительным посевом случаи, зарегистрированные в Соединенных Штатах, были связаны с завозом Corynebacterium diphtheriae, организм считается стать редкостью или исчезнуть из Соединенных Штатов. Однако случай заражения токсигенной C. diphtheriae, обнаруженный в 1996 г. показали, что бактерия остается там, где болезнь было однажды эндемик, такой как индейское сообщество Северных равнин в Южной Дакоте.1 июня 1996 года открытие 62-летней женщины из числа американских индейцев. инфицированные дифтерией привели к усилению эпиднадзора за болезнью среди сообщества. C. diphtheriae был изолирован у 5% из 133 пациентов обследованы в августе-октябре 1996 года. Результаты подчеркивают необходимость для своевременной вакцинации людей всех возрастов на всей территории США.
C. diphtheriae был изолирован у 5% из 133 пациентов обследованы в августе-октябре 1996 года. Результаты подчеркивают необходимость для своевременной вакцинации людей всех возрастов на всей территории США.
продолжение главы
Следующая страница
Дифтерия — AMBOSS
Резюме
Дифтерия — это инфекционное заболевание, вызываемое Corynebacterium diphtheriae, которое обычно передается через дыхательные пути.Клинические признаки дифтерии вызваны токсином, вырабатываемым C. diphtheriae после того, как он колонизирует верхние дыхательные пути. Пациенты изначально обращаются с жаром, недомоганием и болью в горле. В течение нескольких дней на миндалинах, задней стенке глотки и / или гортани развивается серовато-белая псевдомембрана. Другие проявления включают шейную лимфаденопатию, отек мягких тканей шеи, стридор и / или затрудненное дыхание в результате частичной обструкции дыхательных путей. Системная абсорбция токсина может привести к миокардиту, острому некрозу канальцев и / или полинейропатии. Еще до получения положительных результатов по культуре пациентов следует незамедлительно лечить пенициллином и антитоксинами, поскольку нелеченная дифтерия связана с высоким уровнем смертности. В тропических странах также встречается кожная форма дифтерии без системных проявлений. Кожная дифтерия проявляется в виде чешуйчатой эритематозной сыпи и / или глубокой перфорированной язвы после прямого попадания C. diphtheriae в кожу. С момента введения рутинной иммунизации против дифтерии в 1920-х годах заболеваемость в США резко снизилась.
Еще до получения положительных результатов по культуре пациентов следует незамедлительно лечить пенициллином и антитоксинами, поскольку нелеченная дифтерия связана с высоким уровнем смертности. В тропических странах также встречается кожная форма дифтерии без системных проявлений. Кожная дифтерия проявляется в виде чешуйчатой эритематозной сыпи и / или глубокой перфорированной язвы после прямого попадания C. diphtheriae в кожу. С момента введения рутинной иммунизации против дифтерии в 1920-х годах заболеваемость в США резко снизилась.
Эпидемиология
- Заболеваемость: 0–2 случая в год [1]
- Большинство случаев встречается у пациентов в возрасте 20 лет и старше.
Эпидемиологические данные относятся к США, если не указано иное.
Этиология
- Возбудитель: Corynebacterium diphtheriae
- Грамположительная, неспорообразующая, булавовидная палочка
- Содержит метахроматические гранулы (гранулы волютина; красное пятно с синим красителем)
- Путь заражения
- Капельная передача
- Реже прямой или косвенный контакт с открытыми поражениями
- Инфекционный период: переменный
Каталожные номера: [2]
Патофизиология
ABCDEFG C. дифтерия: АДФ-рибозилирование, бета-профаг, булавовидная форма, дифтерия, фактор удлинения 2, метахроматические гранулы.
дифтерия: АДФ-рибозилирование, бета-профаг, булавовидная форма, дифтерия, фактор удлинения 2, метахроматические гранулы.
Каталожные номера: [2] [3] [4]
Клинические особенности
Дифтерия дыхательных путей
Пациент сначала поступает с продромальными симптомами: лихорадка, недомогание и боль в горле. Через 4–5 дней после появления продромальных симптомов возникают симптомы, обусловленные местным и системным действием токсина.
- Инкубационный период: 2–5 дней.
- Местные особенности
- Системные признаки (из-за распространения токсина)
Кожная дифтерия
Литература: [3]
Диагностика
- Посев мазков из глотки: для подтверждения диагноза
- Микроскопическое исследование мазков из глотки или культуральных изолятов выявляет множественные C.
 diphtheriae сгруппированы в угловые группы.
diphtheriae сгруппированы в угловые группы. - Выбранные питательные среды
- Микроскопическое исследование мазков из глотки или культуральных изолятов выявляет множественные C.
- Другие тесты: используются для определения токсикогенности штамма после выявления в культуре C. diphtheriae
- Элек-тест
- Тест иммунопреципитации, в котором C. diphtheriae выращивают в агаризованной культуре, залитой пропитанной антитоксином фильтровальной бумагой
- Положительно, если штамм токсикогенен
- Полимеразная цепная реакция: для идентификации токсического гена
- Элек-тест
- Тест на миокардит: сделайте несколько ЭКГ и последовательно измерьте сердечные маркеры.
Терапию следует начинать сразу же при появлении клинического подозрения, даже до диагностического подтверждения дифтерии.
Дифференциальный диагноз
Перечисленные здесь дифференциальные диагнозы не являются исчерпывающими.
Лечение
- При подозрении на дифтерию пациента следует изолировать.
- Антибактериальная терапия; : Внутримышечные инъекции пенициллина G или эритромицин перорально / внутривенно в течение 14 дней.

- Немедленное введение дифтерийного антитоксина: антитоксин может нейтрализовать только несвязанный токсин, поэтому его следует вводить на ранней стадии развития болезни.
- Продолжительность дифтерии гортани / глотки: 20 000–40 000 единиц внутривенно за 60 минут
- Дифтерия носоглотки: 40 000–60 000 единиц внутривенно за 60 минут
- Бычья шея или дифтерия продолжительностью> 3 дней: 80 000–120 000 единиц внутривенно за 60 минут 9014
- Поддержка дыхательных путей
Введение антитоксина является важной частью лечения, поскольку клинические признаки дифтерии вызваны не самим патогеном, а экзотоксином, который C.diphtheriae производит.
Каталожные номера: [2] [5]
Профилактика
Предэкспозиционная профилактика
Постконтактная профилактика
Постконтактная профилактика показана для близких личных контактов и лиц, ухаживающих за пациентом с дифтерией.
Дифтерия — болезнь, подлежащая регистрации.
Каталожные номера: [5] [6] [7] [8] [9] [10]
Дифтерия: общие сведения, патофизиология, эпидемиология
Автор
Брюс М Ло, MD, MBA, CPE, RDMS, FACEP, FAAEM, FACHE Начальник отделения неотложной медицины, больница общего профиля в Сентаре Норфолк; Врач-врач центра трансфера Sentara; Профессор и помощник директора программы, Основной академический факультет, Департамент неотложной медицины, Медицинская школа Восточной Вирджинии; Член правления Американской академии экстренной медицины
Брюс М Ло, доктор медицины, магистр делового администрирования, CPE, RDMS, FACEP, FAAEM, FACHE является членом следующих медицинских обществ: Американской академии экстренной медицины, Американской ассоциации руководителей врачей, Американского колледжа врачей неотложной помощи, Американский колледж руководителей здравоохранения, Американский институт ультразвука в медицине, Ассоциация медсестер скорой помощи, Медицинское общество Вирджинии, Норфолкская медицинская академия, Общество академической неотложной медицины
Раскрытие: Ничего не раскрывать.
Специальная редакционная коллегия
Франсиско Талавера, фармацевт, доктор философии Адъюнкт-профессор, Фармацевтический колледж Медицинского центра Университета Небраски; Главный редактор Medscape Drug Reference
Раскрытие информации: Получил зарплату от Medscape за работу. для: Medscape.
Барри Дж. Шеридан, DO Главный воин в переходных службах, Медицинский центр армии Брука
Барри Дж. Шеридан, DO является членом следующих медицинских обществ: Американская академия экстренной медицины
Раскрытие: нечего раскрывать.
Главный редактор
Джетер (Джей) Притчард Тейлор, III, доктор медицины Доцент кафедры хирургии Медицинской школы Университета Южной Каролины; Лечащий врач, клинический инструктор, специалист по комплаенсу, отделение неотложной медицины, больница Palmetto Richland
Джетер (Джей) Притчард Тейлор, III, доктор медицинских наук, является членом следующих медицинских обществ: Американской академии неотложной медицины, Американского колледжа врачей неотложной помощи, Американская медицинская ассоциация, Колумбийское медицинское общество, Общество академической неотложной медицины, Колледж врачей неотложной помощи Южной Каролины, Медицинская ассоциация Южной Каролины
Раскрытие информации: Служить (d) в качестве директора, должностного лица, партнера, сотрудника, советника, консультанта или попечителя для: Наемный подрядчик — главный редактор Medscape.
Дополнительные участники
Стивен Конрад, доктор медицины, доктор медицинских наук Заведующий отделением неотложной медицины; Руководитель многопрофильной службы интенсивной терапии, профессор кафедры неотложной медицинской помощи и внутренней медицины, Центр медицинских наук Университета штата Луизиана
Стивен Конрад, доктор медицинских наук, является членом следующих медицинских обществ: Американского колледжа грудных врачей, Американского колледжа критических врачей. Медицинская медицина, Американский колледж врачей неотложной помощи, Американский колледж врачей, Международное общество трансплантации сердца и легких, Медицинское общество штата Луизиана, Шоковое общество, Общество академической неотложной медицины, Общество неотложной медицинской помощи
Раскрытие информации: раскрывать нечего.
Благодарности
Allysia M Guy, MD Штатный врач, Отделение неотложной медицины, Медицинский центр Нижнего штата Нью-Йорка
webmd.com»> Раскрытие: Ничего не раскрывать.Лоренцо Паладино, доктор медицины Доцент, отделение неотложной медицины, Научный центр здоровья SUNY в Бруклине; Консультант, помощник директора по исследованиям, отделение неотложной медицины, больничный центр графства Кингс
Лоренцо Паладино, доктор медицины, является членом следующих медицинских обществ: Alpha Omega Alpha
Раскрытие: Ничего не раскрывать.
Автор: Эльзбета Пилат, MD Штатный врач, Отделение неотложной медицины, Государственный университет Нью-Йорка, Нижний штат Нью-Йорк, Госпитальный центр округа Кингс
Раскрытие: Ничего не раскрывать.
Марк А. Сильверберг, доктор медицины, MMB, FACEP Ассистент-профессор, заместитель директора резидентуры, Департамент неотложной медицины, Медицинский колледж Нижнего штата Нью-Йорка; Персонал-консультант, Отделение неотложной медицины, Университетская больница Статен-Айленда, Больница округа Кингс, Университетская больница, Медицинский центр в Нижнем штате Нью-Йорка
webmd.com»> Марк А. Сильверберг, доктор медицинских наук, MMB, FACEP является членом следующих медицинских обществ: Американского колледжа врачей скорой помощи, Американской медицинской ассоциации, Совета директоров резидентур по неотложной медицине и Общества академической неотложной медициныРаскрытие: Ничего не раскрывать.
Малини К Сингх, MD Старший врач, Отделение неотложной медицины, Медицинский центр Якоби / Монтефиоре
Раскрытие: Ничего не раскрывать.
| Определение (MEDLINEPLUS) | Дифтерия — серьезная бактериальная инфекция.Вы можете заразиться от человека, который кашляет или чихает, у которого есть инфекция. Вакцина против дифтерии, коклюша и столбняка (АКДС) может предотвратить дифтерию, но ее защита не длится вечно.Взрослые должны получать новую дозу или ревакцинацию каждые 10 лет. Дифтерия очень редко встречается в Соединенных Штатах из-за вакцины. Центры по контролю и профилактике заболеваний |
| Определение (NCI) | Грамположительная бактериальная инфекция, вызванная Corynebacterium diphtheria.Обычно он затрагивает полость рта, глотку и носовую полость. У пациентов появляются псевдомембраны в пораженных областях и проявляются признаки и симптомы инфекции верхних дыхательных путей. Токсин дифтерии может вызывать миокардит, полиневрит и другие системные эффекты. У пациентов появляются псевдомембраны в пораженных областях и проявляются признаки и симптомы инфекции верхних дыхательных путей. Токсин дифтерии может вызывать миокардит, полиневрит и другие системные эффекты. |
| Определение (MSH) | Локализованная инфекция слизистых оболочек или кожи, вызванная токсигенными штаммами CORYNEBACTERIUM DIPHTHERIAE.Для него характерно наличие псевдомембраны в месте заражения. ДИФТЕРИЧЕСКИЙ ТОКСИН, продуцируемый C. diphtheriae, может вызывать миокардит, полиневрит и другие системные токсические эффекты. |
| Определение (CSP) | локализованная инфекция слизистых оболочек или кожи, вызванная токсигенными штаммами Corynebacterium diphtheriae; для него характерно наличие псевдомембраны в месте заражения; дифтерийный токсин, продуцируемый C. diphtheriae, может вызывать миокардит, полиневрит и другие системные токсические эффекты. diphtheriae, может вызывать миокардит, полиневрит и другие системные токсические эффекты. |
| Концепции | Заболевание или синдром ( T047 ) |
| MSH | D004165 |
| ICD9 | 032.9, 032 |
| ICD10 | A36 , А36.9 |
| SnomedCT | 154299004, 186349009, 187323007, 3739008, 397428000, 276197005 |
| LNC | LA10452-3 |
| Английский | Дифтерия, дифтерия, дифтерия неуточненная, [X] Дифтерия неуточненная, дифтерия, дифтерия (диагноз), дифтерия БДУ, дифтерия [заболевание / обнаружение], дифтерия БДУ (нарушение), коринебактерия (дифтерия, неуточненная инфекция) ), Инфекция, вызванная Corynebacterium diphtheriae, Дифтерия (заболевание), Инфекция, вызванная Corynebacterium diphtheriae (заболевание), дифтерийная; инфекция, инфекция; Corynebacterium diphtheriae, инфекция; дифтерийные, Corynebacterium diphtheriae; инфекция, дифтерия, БДУ |
| Голландский | diffterie, niet-gespecificeerd, Corynebacterium diphtheriae-influenctie, Corynebacterium diphtheriae; Инфекция, дифтерич; инфекция, инфекция; Corynebacterium diphtheriae, инфекция; diffterisch, Difterie, niet gespecificeerd, difterie, Difterie |
| французский | Diphtérie, nonprécisée, Infection à Corynebacterium diphtheriae, Diphtérie |
| немецкий | Diphtherie, unspezifisch, Corynebacterium diphtheriae-Infektion, Diphtherie, nicht naeher bezeichnet, Diphtherie |
| Итальянский | Infezione da Corynebacterium diphtheriae, Difterite non specificata, Difterite |
| Португальский | Difteria NE, Infecção por Corynebacterium diphtheriae, Difteria |
| Испанский | Infección por Corynebacterium diphtheriae, Difteria no especificada, [X] difteria, no especificada, [X] diffteria, no especificada (trastorno), diffteria, SAI, инфекция por Corynebacterium diphteriae, difteria, SAI (trastorno), дифтерия, дифтерия , Инфекция пор Corynebacterium diphtheriae (trastorno), Инфекция пор Corynebacterium diphtheriae, Difteria |
| Японский | ジ フ テ リ ア 、 不明, ジ フ テ リ ア, コ リ ネ バ ク テ ム ・ ジ フ テ リ ア 感染, ジ フ テ リ ア シ ョ ウ フ メ メ, コ, |
| Шведский | Дифтери |
| Чешский | záškrt, Infekce způsobená Corynebacterium diphteriae, Difterie, Difterie, blíže nerčená, difterie, diftérie, mázdřivka |
| финский | Курккуматя |
| Русский | ДИФТЕРИЯ, ДИФТЕРИЯ |
| корейский | 디프테리아, 상세 불명 의 디프테리아 |
| Польский | Dyfteryt, Błonica, Zakażenie Corynebacterium diphtheriae |
| Венгерский | дифтерия, nem meghatározott, дифтерия, Corynebacterium diphtheriae fertőzés |
| норвежский | Дифтери |
Дифтерия
Дифтерия Дифтерия- острое заразное заболевание
- Дифтерия является результатом местного и системного действия дифтерии.
 токсин.
токсин. - Характеризуется образованием мембран в горле.
- Инфекция может вызвать болезнь или состояние носительства
- Дифтерия — болезнь детей
Corynebacterium diphtheriae
- Люди — единственный резервуар инфекции
- Аэробный, булавовидный, грамположительный, неподвижный, неинкапсулированный, плеоморфный палочка с концевым вздутием
- При окрашивании часто встречается группами, которые образуют острые углы с каждым другие и напоминают китайские буквы.
- Дети, не вакцинированные от C. diphtheria.
- С ослабленным иммунитетом
- Плохо иммунизированные взрослые
- Респираторные капли
- Выделения из носоглотки
- Прямой контакт с кожной инфекцией
- Фомиты
 Организмы могут выжить в пыли и одежде до 6 месяцев.
Организмы могут выжить в пыли и одежде до 6 месяцев.Патогенные механизмы
Заболевание вызывается экзотоксином, подавляющим синтез белка эукариотические клетки
Токсин содержит токсичную субъединицу A (активный токсин) и рецептор связывающая субъединица B.
Субъединица В (фрагмент) способствует транслокации Субъединица от фагосомы до цитозоля с последующим разделением, обеспечение полной активности субъединицы A по удлинению целевого белка фактор-2.EF-2 переносит полипептидил-переносящую РНК от акцептора к донору сайты на рибосоме клетки-хозяина.
Субъединица A катализирует перенос аденин-рибозы фосфат от НАД до EF-2 (рибозилирование АДФ), инактивирующий EF-2 и выключая синтез белка, токсин C. diphtheria способен подавлять синтез белков всех эукариотических клеток.

Фрагмент А обладает ферментативной активностью
Фрагмент B прикрепляется к клеточным рецепторам и предоставляет фрагмент А вход в клетку, где он подавляет синтез белка.
Экзотоксин i всасывается в кровоток и распространены, приводя к системным осложнениям, включая демиелинизирующие невриты и миокардиты.
Токсин дифтерии также вызывает локальное разрушение сайт образования мембраны .
Ген токсина
Ген токсина дифтерии находится в геноме бактериофаг.
Штаммы C. diphtheria должны содержать бактериофаг (бета-фаг), приобретенный путем трансдукции от других штаммов C. diphtheria, в для того, чтобы выразить токсин.
После трансдукции фаг необходимо лизогенизировать.

Экспрессия токсина (ген лисы) регулируется кодируемый хромосомами репрессорный белок (DtxR) при ограничении содержания железа.
- Похоже, у нас нет никакой защиты от токсина.Защита есть обеспечивается только вакцинацией.
- С организмами борются?
Инкубационный период 2-5 суток
Дифтерия — результат местных и системных эффектов дифтерии. токсин.
Летальность в нелеченых случаях составляет 10-50%.
ДиагностикаПервоначальный диагноз клинический
Нет экспресс-теста в лаборатории
Окраска горла по Граму бесполезна
Организм можно культивировать для подтверждения диагноза.Пропущенный на обычных культурах.
 Сообщите в лабораторию о возможном диагнозе.
Сообщите в лабораторию о возможном диагнозе. Производство токсинов культивируемых штаммов может осуществляться иммунодиффузия.
Сыворотка на антитела к дифтерийному токсину
Другие полезные оценки
ЭКГ и сердечные ферменты для выявления миокардита
CXR: гиперинфляция, подсвязочное сужение
Строгая изоляция
С.diphtheriae антитоксин дается незамедлительно для нейтрализации токсин.
Обратитесь в CDC за антитоксином и инструкциями по применению.
Не ждать для подтверждения культуры.
Антитела, вырабатываемые против токсина в естественных инфекционное заболевание.

Обработайте токсином, чтобы нейтрализовать свободный токсин перед этим связывается с клетками.
Сам организм можно лечить пенициллином , цефалоспорины и эритромицин.
Сообщить в отдел здравоохранения
Клиническая дифтерия не дает иммунитета, следовательно, активная иммунизация дифтерийным анатоксином должна проводиться во время выздоровление.
Бронходилататоры при необходимости.
Следите за респираторной обструкцией и примите необходимые шаги.
Следите за миокардитом и чесоткой соответствующим образом
- Своевременная вакцинация
- Дифтерия: иммунизация анатоксином вызывает
ответ антител, предотвращающий заражение дифтерией.

- Вакцинация анатоксином = токсин, обработанный формалином
- Дифтерия: иммунизация анатоксином вызывает
ответ антител, предотвращающий заражение дифтерией.
- Бустерная доза столбняка-дифтерии каждые 10 лет до взрослого возраста
- Надзор в сообществах, где дифтерия была эндемичной
- Замкнуть контакты
- Следует выявить и лечить пероральным эритромицином для 7-10 дней
- Провести активную иммунизацию
Прочие виды
Corynebacterium ulcerans:
- Кожная дифтерия
- Обычно вызывается токсическими штаммами.
- Создает естественный иммунитет
- Может вызывать эпидемии у плохо иммунизированных групп населения.
Определение дифтерии на Dictionary.com
[diff-theer-ee-uh, dip-] SHOW IPA
/ dɪfˈθɪər i ə, dɪp- / PHONETIC RESPELLING
сущ Патология.

фебрильное инфекционное заболевание, вызываемое палочкой Corynebacterium diphtheriae и характеризующееся образованием ложной мембраны в дыхательных путях, особенно в горле.
ВОПРОСЫ
ПРОГНОЗИРУЙТЕ СЕБЯ ИМЕЕТ ПРОТИВ. ИМЕЮТ!
У вас есть грамматические навыки, чтобы знать, когда использовать «иметь» или «иметь»? Давайте узнаем это с помощью этой викторины!
Вопрос 1 из 7
Моя бабушка ________ Стена полная старинных часов с кукушкой.
Происхождение дифтерии
1850–55; diphthériediphthér (a) кожа, кожа + -ia-iaСлова рядом с дифтерией
дифенилкетон, дифония, дифосген, дифосфат, дифосфоглицерат, дифтерия, дифтерийный антитоксин, дифтерийный, столбнячный токсоиды, дифтероидная вакцина, дифтероидная вакцина000 .com Несокращенный На основе Несокращенного словаря Random House, © Random House, Inc. 2021
Примеры предложений из Интернета по дифтерии
Первая Нобелевская премия по физиологии и медицине была присуждена Эмилю фон Берингу в 1901 году за его работу по изучению сывороточной терапии при дифтерии.

Один из его братьев умер от дифтерии во время блокады Ленинграда нацистами во время Второй мировой войны.
Дифтерия, с другой стороны, вполне способна вызвать вспышку среди уязвимого населения.
К счастью, в Соединенных Штатах дифтерия практически ликвидирована.
Напротив, озабоченность отражает тот факт, что в отличие от кори, дифтерии или краснухи, ВПЧ не передается при случайном контакте.
Его оптимизм побудил его сравнить искоренение бедности с искоренением скарлатины и дифтерии.
Фибринозные цилиндры характерны для фибринозного бронхита, но также могут быть обнаружены при дифтерии более мелких бронхов.
Из стоячей лужи вылетает микроб, и смеющийся ребенок, любимец его матери, ужасно умирает от дифтерии.
Псевдомембранозный конъюнктивит обычно проявляется либо стрептококками, либо дифтерийной палочкой.
До тех пор, пока подавляющее большинство христиан не будут касаться сточных вод, дифтерия должна продолжаться.

У школьников иногда бывает то, что кажется простой болью в горле, но на самом деле у людей с естественным иммунитетом это дифтерия.
дифтерия
/ (dɪpˈθɪərɪə, dɪf-) /
существительное
острая инфекционная инфекция, вызываемая острой инфекционной палочкой прострация, затруднение дыхания и глотания в результате набухания горла и образования ложной мембраны
Производные формы дифтерии
дифтерийный, дифтерийный (ˌdɪpθəˈrɪtɪk, dɪf-) или дифтерийный (dɪpˈθɛrɪkroid, adftheria, dɪftheria) прилагательноеПроисхождение слова дифтерия
C19: Новая латынь, от французского diphthérie, от греческой кожи дифтеры; от природы мембраны
Collins English Dictionary — Complete & Unabridged 2012 Digital Edition
© William Collins Sons & Co. Ltd. 1979, 1986 © HarperCollins
Издательство 1998, 2000, 2003, 2005, 2006, 2007, 2009, 2012
Ltd. 1979, 1986 © HarperCollins
Издательство 1998, 2000, 2003, 2005, 2006, 2007, 2009, 2012
дифтерия
[df-thîr′ē-ə, dĭp-]
n.
Острое инфекционное заболевание, вызываемое Corynebacterium diphtheriae и характеризующееся выработкой системного токсина и образованием ложной мембраны на слизистой оболочке горла и других дыхательных путей, вызывающей затруднение дыхания, высокую температуру, и слабость. Токсин особенно вреден для тканей сердца и центральной нервной системы.
Другие слова из дифтерии
diph′the • rit′ic (-thə-rĭt′ĭk) null null прил.Медицинский словарь American Heritage® Стедмана Авторское право © 2002, 2001, 1995 компанией Houghton Mifflin. Опубликовано компанией Houghton Mifflin.
дифтерия
[dĭf-thîr′ē-ə, dĭp-]
Инфекционное заболевание, вызываемое бактерией Corynebacterium diphtheriae и характеризующееся лихорадкой, опухшими железами и образованием мембраны в горле, препятствующей дыхание.









 Инфицированы гортань и трахея.
Инфицированы гортань и трахея.


 При необходимости может быть назначен плазмаферез (фильтрация плазмы крови) для очищения от токсических веществ.
При необходимости может быть назначен плазмаферез (фильтрация плазмы крови) для очищения от токсических веществ.

 diphtheriae сгруппированы в угловые группы.
diphtheriae сгруппированы в угловые группы.
 Обычно он поражает нос и горло и вызывает сильную боль в горле, опухшие железы, жар и озноб. Но если его не диагностировать и не лечить, он производит яд в организме, который может вызвать серьезные осложнения, такие как сердечная недостаточность или паралич.
Обычно он поражает нос и горло и вызывает сильную боль в горле, опухшие железы, жар и озноб. Но если его не диагностировать и не лечить, он производит яд в организме, который может вызвать серьезные осложнения, такие как сердечная недостаточность или паралич. токсин.
токсин.

 Сообщите в лабораторию о возможном диагнозе.
Сообщите в лабораторию о возможном диагнозе.